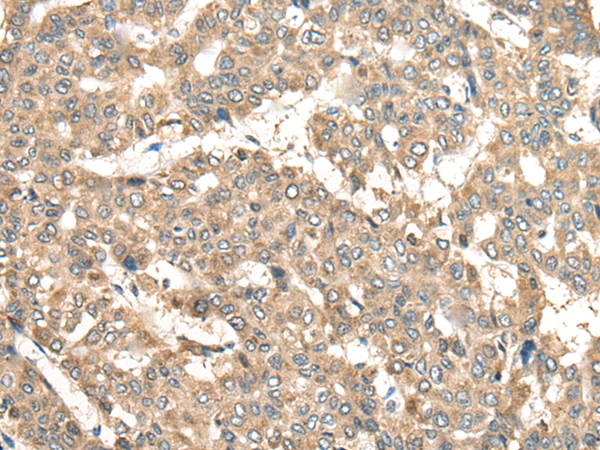

中文名稱: 兔抗ADRA2A多克隆抗體
|
Background: |
Alpha-2-adrenergic receptors are members of the G protein-coupled receptor superfamily. They include 3 highly homologous subtypes: alpha2A, alpha2B, and alpha2C. These receptors have a critical role in regulating neurotransmitter release from sympathetic nerves and from adrenergic neurons in the central nervous system. Studies in mouse revealed that both the alpha2A and alpha2C subtypes were required for normal presynaptic control of transmitter release from sympathetic nerves in the heart and from central noradrenergic neurons; the alpha2A subtype inhibited transmitter release at high stimulation frequencies, whereas the alpha2C subtype modulated neurotransmission at lower levels of nerve activity. This gene encodes alpha2A subtype and it contains no introns in either its coding or untranslated sequences. |
|
Applications: |
ELISA, WB, IHC |
|
Name of antibody: |
ADRA2A |
|
Immunogen: |
Synthetic peptide of human ADRA2A |
|
Full name: |
adrenoceptor alpha 2A |
|
Synonyms: |
ADRA2; ADRAR; ZNF32; ADRA2R; ALPHA2AAR |
|
SwissProt: |
P08913 |
|
ELISA Recommended dilution: |
5000-10000 |
|
IHC positive control: |
Human liver cancer |
|
IHC Recommend dilution: |
25-100 |
|
WB Predicted band size: |
49 kDa |
|
WB Positive control: |
Human left thymus tissue lysate |
|
WB Recommended dilution: |
200-1000 |

購物車
購物車 幫助
幫助
 021-54845833/15800441009
021-54845833/15800441009
